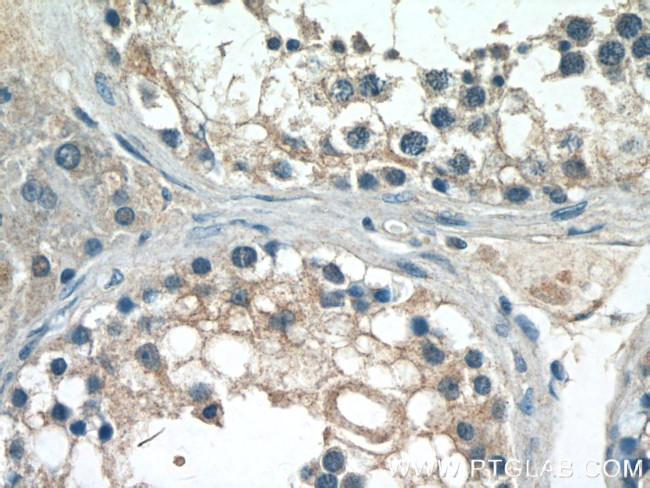
CST9L Antibody in Immunohistochemistry (Paraffin) (IHC (P))

Search
Proteintech
CST9L Polyclonal Antibody
{{$productOrderCtrl.translations['antibody.pdp.commerceCard.promotion.promotions']}}
{{$productOrderCtrl.translations['antibody.pdp.commerceCard.promotion.viewpromo']}}
{{$productOrderCtrl.translations['antibody.pdp.commerceCard.promotion.promocode']}}: {{promo.promoCode}} {{promo.promoTitle}} {{promo.promoDescription}}. {{$productOrderCtrl.translations['antibody.pdp.commerceCard.promotion.learnmore']}}
产品信息
13649-1-AP
种属反应
宿主/亚型
分类
类型
抗原
偶联物
形式
浓度
规格
纯化类型
保存液
内含物
保存条件
运输条件
产品详细信息
Immunogen sequence: WHFHEQRDC DEHNVMARYL PATVEFAVHT FNQQSKDYYA YRLGHILNSW KEQVESKTVF SMELLLGRTR CGKFEDDIDN CHFQESTELN NTFTCFFTIS TRPWMTQFSL LNKTCLEGFH (29-147 aa encoded by BC029656)
靶标信息
The cystatin superfamily is a well-established family of cysteine protease inhibitors. All true cystatins inhibit cysteine peptidases of the papain family, such as cathepsins, while some also inhibit legumain family enzymes. CST9L (Cystatin-9-like) is a 147 amino acid secreted protein that is related to cystatin 9, which is thought to play a role in hematopoietic differentiation or inflammation. The gene encoding CST9L maps to human chromosome 20, which comprises approximately 2% of the human genome and contains nearly 63 million bases that encode over 600 genes, some of which are associated with Creutzfeldt-Jakob disease, amyotrophic lateral sclerosis, spinal muscular atrophy, ring chromosome 20 epilepsy syndrome and Alagille syndrome. Additionally, chromosome 20 contains a region with numerous genes which are thought important for seminal production and may be potential targets for male contraception.
仅用于科研。不用于诊断过程。未经明确授权不得转售。
篇参考文献 (0)
生物信息学
蛋白别名: Cystatin-9-like; Testatin; testicular tissue protein Li 45; unnamed protein product
基因别名: bA218C14.1; CST9L; CTES7B; UNQ1835/PRO3543
UniProt ID: (Human) Q9H4G1
Entrez Gene ID: (Human) 128821